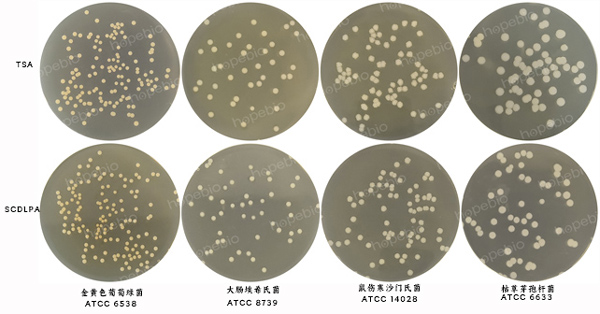

海博微信公众号
海博微信公众号
 海博天猫旗舰店
海博天猫旗舰店


 海博微信公众号
海博微信公众号
 海博天猫旗舰店
海博天猫旗舰店




一、产品用途及原理
用途:本培养基用于环境、器皿、设备和表面的无菌检测。
原理:胰酪蛋白胨和大豆蛋白胨为微生物的生长提供碳氮源、维生素和生长因子;氯化钠维持均衡的渗透压;卵磷脂作为表面活性剂,可以起到中和防腐剂的作用;吐温80可以促进微生物的生长繁殖;琼脂是培养基的凝固剂。
二、培养基配方(g/L)
|
胰酪蛋白胨 |
15.0 |
|
大豆蛋白胨 |
5.0 |
|
氯化钠 |
5.0 |
|
卵磷脂 |
1.0 |
|
吐温80 |
7.0 |
|
琼脂 |
15.0 |
|
pH值7.3±0.2(25℃) |
|
三、试验方法
1、称取本品45.7g,加热搅拌溶解于1000mL蒸馏水中,121℃高压灭菌15min,倾入无菌平皿中,备用。
2、制备质控菌液接种到SCDLPA培养基以及参比培养基TSA上。
3、放置于30℃-35℃需氧培养18h-24h。
四、结果观察
接种以下质控菌株,放置于30℃-35℃需氧培养18h-24h。培养结果如图1。
|
质控菌株 |
菌株编号 |
接种量(CFU) |
回收率 |
生长情况 |
其它特征 |
|
金黄色葡萄球菌 |
ATCC 6538 |
10-100 |
≥70% |
+++ |
有黄色色素 |
|
大肠埃希氏菌 |
ATCC 8739 |
10-100 |
≥70% |
+++ |
无色透明大菌落 |
|
鼠伤寒沙门氏菌 |
ATCC 14028 |
10-100 |
≥70% |
+++ |
无色大菌落 |
|
枯草芽孢杆菌 |
ATCC 6633 |
10-100 |
≥70% |
+++ |
白色不规则菌落 |
|
铜绿假单胞菌 |
ATCC 9027 |
10-100 |
≥70% |
+++ |
有绿色色素 |
|
白色念珠菌 |
ATCC 10231 |
10-100 |
≥70% |
+++ |
白色菌落(培养48h-72h) |
|
黑曲霉 |
ATCC 16404 |
10-100 |
≥70% |
+++ |
有黑色孢子(培养48h-72h) |

图1 大豆酪蛋白消化物卵磷脂吐温80琼脂培养基(SCDLPA)的微生物质控结果
相关产品:
注:本文属海博生物原创,未经允许不得转载。



